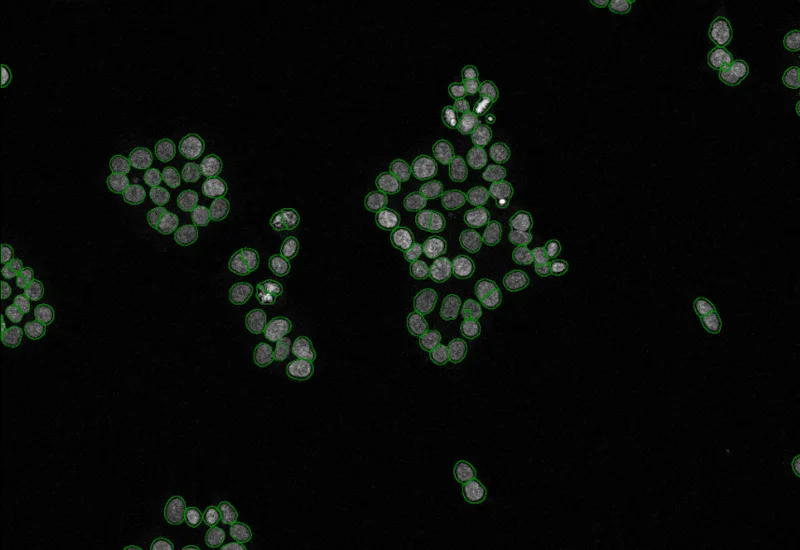

IF Membrane
Detect nuclei, segment cells into membrane, cytoplasm, and nuclei, and quantify marker intensity, stained area, membrane length, angle, and percentage of positive cells per compartment.
intracellular analysis
single-cell analysis
cell culture
spheroid, membrane

The IF Membrane App detects nuclei and segments the cells into different cellular compartments including membrane, nuclei and cytoplasm. It detects one additional marker (e.g. HER2/neu). Each segmented cell compartment is measured for different parameters such as staining intensity, stained area, number/percentage of marker positive cells etc. within the detected cellular compartments. Three more parameters are measured for membrane including membrane area, membrane length and angle of staining.

Original Image
Nuclei detection

Membrane detection

Nuclei and cytoplasm detection
cell culture

Webinar
19 Nov, 2024
Quantification of p-H2AX Foci in Co-cultured Cells Exposed to Radiation, Livia Sima
single-cell analysis

White Paper
30 Mar, 2026
Understanding NeuroCOVID-19: SARS-CoV-2 Disrupts Astrocyte Homeostatic Functions
intracellular analysis

Application Note
14 Oct, 2024
Quantitative Analysis of Cultured Cells
We support the following file formats:
- TissueFAXS (aqproj)
- StrataFAXS II (vmic)
- PreciPoint (vmic, gtif)
- Generic BigTIFF Import
- Support for multipage BigTIFF files
- OME-TIFF
- JPEG, PNG, BMP, TIFF
- Zeiss (czi)
- Hamamatsu NanoZoomer (ndpi)
- Aperio (svs)
- Leica (scn)
- 3D HISTECH Pannoramic
- Mirax (mrxs)
- Olympus (vsi)
- More slide scanners to be added!
Related Apps

IF Cardio Cell Culture Dots
Segment cultured cardiac cells, detect cardiomyocytes and fibroblasts, and quantify dot markers (CISH/FISH) per cell, including cell counts and dot number, area, and mean intensity.
cardiology, cardiomyocytes, cell culture, fibroblasts, troponin red, FISH

IHC Membrane
Unmix up to three markers in IHC/HC slides, segment cells into nucleus, perinuclear area, cytoplasm, and membrane (e.g. HER2/neu), measure up to 20 intensity, statistic, and morphometric parameters per compartment plus membrane intensity and angle.
HER2, breast cancer, immunohistochemistry, automated scoring

Custom App development
Perfectly tailored image analysis solutions for your research.
You have a specific research question that needs to be answered? We offer custom development of image analysis pipelines for specific tasks, be it detection of cellular phenotypes or quantification of tissue structures. After discussing your goals with one of our experts, you will get a ready-to-use App and be a step closer to an impactful publication.

